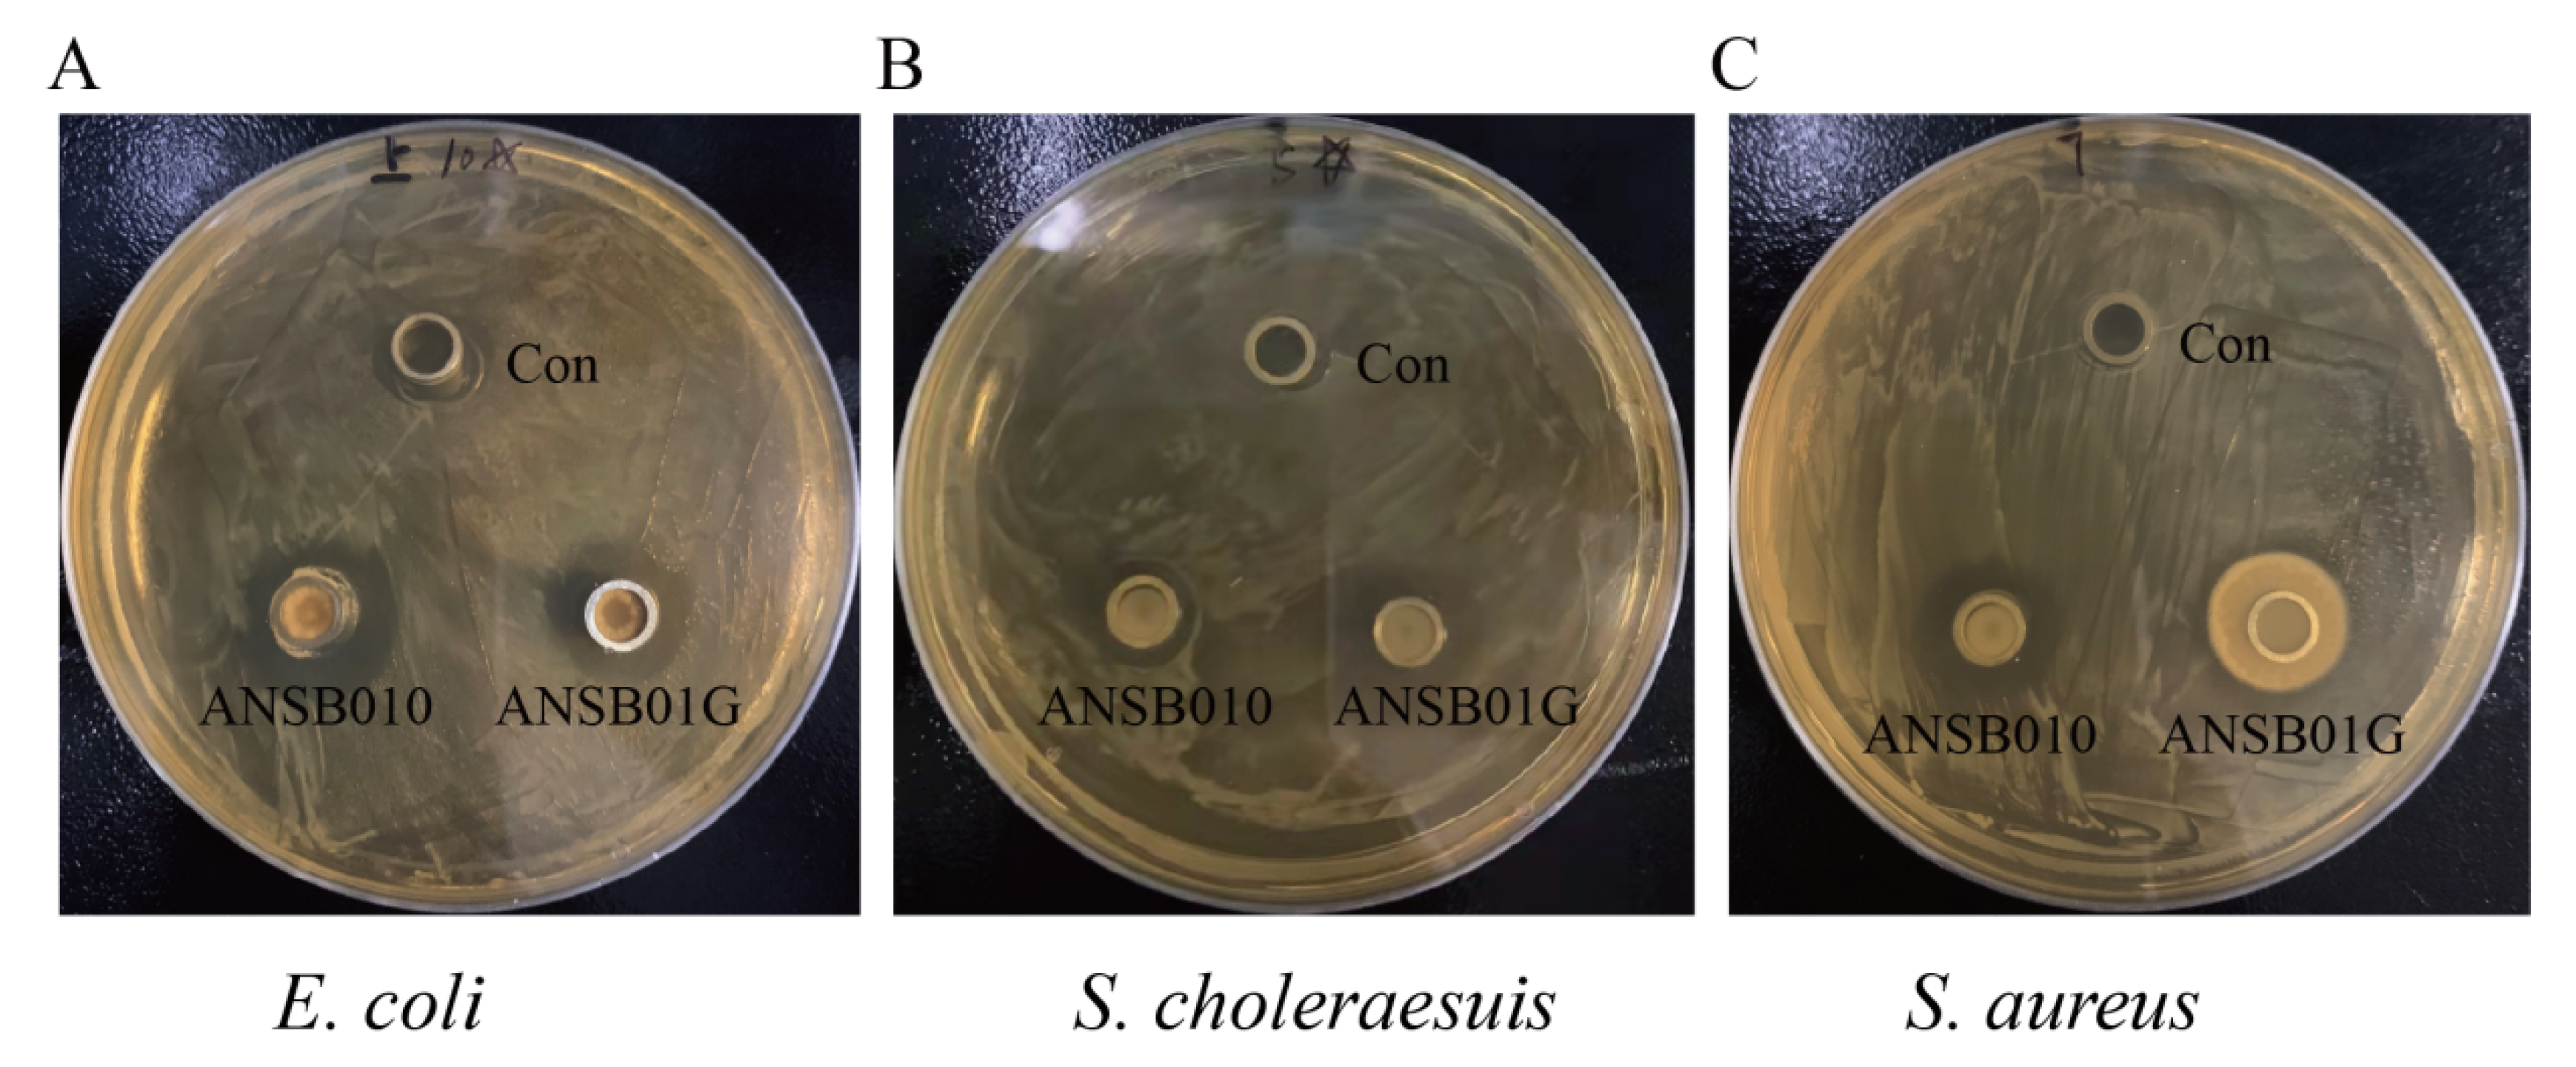
Toxins 13 00882 g002

Comparison of Ameliorative Effects between Probiotic and Biodegradable Bacillus subtilis on Zearalenone Toxicosis in Gilts
Abstract
:1. Introduction
2. Results
2.1. Biochemical and Physiological Characteristics of Bacillus subtilis ANSB010 and ANSB01G
2.2. Bacteriostatic and ZEN-Degrading Effects of ANSB010 and ANSB01G
2.3. Growing Performance
2.4. Vulva Size
2.5. Serum Biochemical Indicators, Antioxidant and Immunology Parameters
2.6. Serum Hormone Parameters
2.7. ZEN Residues
3. Discussion
4. Conclusions
5. Materials and Methods
5.1. Source and Identification of Bacterial Strains
5.2. Antibacterial Activity and ZEN Degradation Tests
5.3. Animals and Experimental Treatments
5.4. Growth Performances
5.5. Vulva Size Determination
5.6. Serum Parametes
5.7. Determination of ZEN in the Feed, Feces, Broth and Serum
5.8. Statistical Analysis
Supplementary Materials
Author Contributions
Funding
Institutional Review Board Statement
Informed Consent Statement
Data Availability Statement
Acknowledgments
Conflicts of Interest
References
- Kuiper-Goodman, T.; Scott, P.; Watanabe, H. Risk assessment of the mycotoxin zearalenone. Regul. Toxicol. Pharmacol. 1987, 7, 253–306. [Google Scholar] [CrossRef]
- Zinedine, A.; Soriano, J.M.; Moltó, J.C.; Mañes, J. Review on the toxicity, occurrence, metabolism, detoxification, regulations and intake of zearalenone: An oestrogenic mycotoxin. Food Chem. Toxicol. 2007, 45, 1–18. [Google Scholar] [CrossRef] [PubMed]
- Ma, R.; Zhang, L.; Liu, M.; Su, Y.-T.; Xie, W.-M.; Zhang, N.-Y.; Dai, J.-F.; Wang, Y.; Rajput, S.A.; Qi, D.-S.; et al. Individual and Combined Occurrence of Mycotoxins in Feed Ingredients and Complete Feeds in China. Toxins 2018, 10, 113. [Google Scholar] [CrossRef] [Green Version]
- Döll, S.; Dänicke, S. The Fusarium toxins deoxynivalenol (DON) and zearalenone (ZON) in animal feeding. Prev. Vet. Med. 2011, 102, 132–145. [Google Scholar] [CrossRef] [PubMed]
- Jiang, S.Z.; Yang, Z.B.; Yang, W.R.; Gao, J.; Liu, F.X.; Broomhead, J.; Chi, F. Effects of purified zearalenone on growth performance, organ size, serum metabolites, and oxidative stress in postweaning gilts1. J. Anim. Sci. 2011, 89, 3008–3015. [Google Scholar] [CrossRef] [Green Version]
- Pistol, G.C.; Braicu, C.; Motiu, M.; Gras, M.A.; Marin, D.E.; Stancu, M.; Calin, L.; Israel-Roming, F.; Berindan-Neagoe, I.; Taranu, I. Zearalenone Mycotoxin Affects Immune Mediators, MAPK Signalling Molecules, Nuclear Receptors and Genome-Wide Gene Expression in Pig Spleen. PLoS ONE 2015, 10, e0127503. [Google Scholar] [CrossRef] [Green Version]
- Awad, W.A.; Ghareeb, K.; Böhm, J.; Zentek, J. Decontamination and detoxification strategies for the Fusarium mycotoxin deoxynivalenol in animal feed and the effectiveness of microbial biodegradation. Food Addit. Contam. 2010, 27, 510–520. [Google Scholar] [CrossRef]
- Rustom, I.Y.S. Aflatoxin in food and feed: Occurrence, legislation and inactivation by physical methods. Food Chem. 1997, 59, 57–67. [Google Scholar] [CrossRef]
- Schatzmayr, G.; Zehner, F.; Täubel, M.; Schatzmayr, D.; Klimitsch, A.; Loibner, A.P.; Binder, E.M. Microbiologicals for deactivating mycotoxins. Mol. Nutr. Food Res. 2006, 50, 543–551. [Google Scholar] [CrossRef] [PubMed]
- Jardon-Xicotencatl, S.; Díaz-Torres, R.; Marroquin-Cardona, A.; Villarreal-Barajas, T.; Méndez-Albores, A. Detoxification of Aflatoxin-Contaminated Maize by Neutral Electrolyzed Oxidizing Water. Toxins 2015, 7, 4294–4314. [Google Scholar] [CrossRef] [Green Version]
- Jouany, J.P. Methods for preventing, decontaminating and minimizing the toxicity of mycotoxins in feeds. Anim. Feed. Sci. Technol. 2007, 137, 342–362. [Google Scholar] [CrossRef]
- Doyle, M.P.; Applebaum, R.S.; Brackett, R.E.; Marth, E.H. Physical, Chemical and Biological Degradation of Mycotoxins in Foods and Agricultural Commodities. J. Food Prot. 1982, 45, 964–971. [Google Scholar] [CrossRef]
- Lei, Y.; Zhao, L.; Ma, Q.; Zhang, J.Y.; Zhou, T.; Gao, C.; Ji, C. Degradation of zearalenone in swine feed and feed ingredients by Bacillus subtilis ANSB01G. World Mycotoxin J. 2014, 7, 143–151. [Google Scholar] [CrossRef]
- Zhao, L.; Lei, Y.; Bao, Y.; Jia, R.; Ma, Q.; Zhang, J.; Chen, J.; Ji, C. Ameliorative effects ofBacillus subtilisANSB01G on zearalenone toxicosis in pre-pubertal female gilts. Food Addit. Contam. Part A 2014, 32, 617–625. [Google Scholar] [CrossRef] [PubMed]
- Galvano, F.; Piva, A.; Ritieni, A.; Galvano, G. Dietary Strategies to Counteract the Effects of Mycotoxins: A Review. J. Food Prot. 2001, 64, 120–131. [Google Scholar] [CrossRef] [PubMed]
- Binder, E.M. Managing the risk of mycotoxins in modern feed production. Anim. Feed. Sci. Technol. 2007, 133, 149–166. [Google Scholar] [CrossRef]
- Zaki, M.M.; El-Midany, S.; Shaheen, H.; Rizzi, L. Mycotoxins in animals: Occurrence, effects, prevention and management. J. Toxicol. Environ. Health Sciences 2012, 4, 13–28. [Google Scholar] [CrossRef]
- Huwig, A.; Freimund, S.; Käppeli, O.; Dutler, H. Mycotoxin detoxication of animal feed by different adsorbents. Toxicol. Lett. 2001, 122, 179–188. [Google Scholar] [CrossRef]
- Kološová, A.; Stroka, J. Substances for reduction of the contamination of feed by mycotoxins: A review. World Mycotoxin J. 2011, 4, 225–256. [Google Scholar] [CrossRef]
- Swamy, H.V.L.N.; Smith, T.K.; Macdonald, E.J.; Karrow, N.A.; Woodward, B.; Boermans, H.J. Effects of feeding a blend of grains naturally contaminated with Fusarium mycotoxins on growth and immunological measurements of starter pigs, and the efficacy of a polymeric glucomannan mycotoxin adsorbent. J. Anim. Sci. 2003, 81, 2792–2803. [Google Scholar] [CrossRef]
- Pierzgalski, A.; Bryła, M.; Kanabus, J.; Modrzewska, M.; Podolska, G. Updated Review of the Toxicity of Selected Fusarium Toxins and Their Modified Forms. Toxins 2021, 13, 768. [Google Scholar] [CrossRef]
- Cheng, Y.-H.; Weng, C.-F.; Chen, B.-J.; Chang, M.-H. Toxicity of different Fusarium mycotoxins on growth performance, immune responses and efficacy of a mycotoxin degrading enzyme in pigs. Anim. Res. 2006, 55, 579–590. [Google Scholar] [CrossRef] [Green Version]
- Zhang, J.; Zheng, Y.; Tao, H.; Liu, J.; Zhao, P.; Yang, F.; Lv, Z.; Wang, J. Effects of Bacillus subtilis ZJ-2019-1 on Zearalenone Toxicosis in Female Gilts. Toxins 2021, 13, 788. [Google Scholar] [CrossRef]
- Gao, X.; Xiao, Z.; Li, C.; Zhang, J.; Zhu, L.; Sun, L.; Zhang, N.; Khalil, M.M.; Rajput, S.A.; Qi, D. Prenatal exposure to zearalenone disrupts reproductive potential and development via hormone-related genes in male rats. Food Chem. Toxicol. 2018, 116, 11–19. [Google Scholar] [CrossRef] [PubMed]
- Shi, D.; Zhou, J.; Zhao, L.; Rong, X.; Fan, Y.; Hamid, H.; Li, W.; Ji, C.; Ma, Q. Alleviation of mycotoxin biodegradation agent on zearalenone and deoxynivalenol toxicosis in immature gilts. J. Anim. Sci. Biotechnol. 2018, 9, 42. [Google Scholar] [CrossRef] [PubMed] [Green Version]
- Hassan, A.A.; Rashid, M.; Koratum, K.M. Effect of aflatoxin B1, zearalenone and ochratoxin A on some hormones related to fertility in male rats. Life Sci. J. 2010, 7, 64–72. [Google Scholar]
- Silva, J.R.; Hurk, R.V.D.; de Matos, M.H.T.; dos Santos, R.R.; Pessoa, C.; de Moraes, M.O.; de Figueiredo, J.R. Influences of FSH and EGF on primordial follicles during in vitro culture of caprine ovarian cortical tissue. Theriogenology 2004, 61, 1691–1704. [Google Scholar] [CrossRef] [PubMed]
- Zielonka, L.; Gajęcka, M.; Lisieska-Żołnierczyk, S.; Dąbrowski, M.; Gajęcki, M.T. The Effect of Different Doses of Zearalenone in Feed on the Bioavailability of Zearalenone and Alpha-Zearalenol, and the Concentrations of Estradiol and Testosterone in the Peripheral Blood of Pre-Pubertal Gilts. Toxins 2020, 12, 144. [Google Scholar] [CrossRef] [PubMed] [Green Version]
- Van Le Thanh, B.; Lemay, M.; Bastien, A.; Lapointe, J.; Lessard, M.; Chorfi, Y.; Guay, F. The potential effects of antioxidant feed additives in mitigating the adverse effects of corn naturally contaminated with Fusarium mycotoxins on antioxidant systems in the intestinal mucosa, plasma, and liver in weaned pigs. Mycotoxin Res. 2016, 32, 99–116. [Google Scholar] [CrossRef]
- Zhou, J.; Ao, X.; Lei, Y.; Ji, C.; Ma, Q. Bacillus subtilis ANSB01G culture alleviates oxidative stress and cell apoptosis induced by dietary zearalenone in first-parity gestation sows. Anim. Nutr. 2020, 6, 372–378. [Google Scholar] [CrossRef]
- Long, M.; Yang, S.; Zhang, W.; Zhang, Y.; Li, P.; Guo, Y.; Wang, Y.; Chen, X.; He, J. The Influence of Selenium Yeast on Hematological, Biochemical and Reproductive Hormone Level Changes in Kunming Mice Following Acute Exposure to Zearalenone. Biol. Trace Element Res. 2016, 174, 362–368. [Google Scholar] [CrossRef] [PubMed]
- Su, Y.; Sun, Y.; Ju, D.; Chang, S.; Shi, B.; Shan, A. The detoxification effect of vitamin C on zearalenone toxicity in piglets. Ecotoxicol. Environ. Saf. 2018, 158, 284–292. [Google Scholar] [CrossRef] [PubMed]
- Ben Salah-Abbès, J.; Belgacem, H.; Ezzdini, K.; Abdel-Wahhab, M.A.; Abbès, S. Zearalenone nephrotoxicity: DNA fragmentation, apoptotic gene expression and oxidative stress protected by Lactobacillus plantarum MON03. Toxicon 2020, 175, 28–35. [Google Scholar] [CrossRef]
- Tiemann, U.; Brüssow, K.-P.; Dannenberger, D.; Jonas, L.; Pöhland, R.; Jäger, K.; Dänicke, S.; Hagemann, E. The effect of feeding a diet naturally contaminated with deoxynivalenol (DON) and zearalenone (ZON) on the spleen and liver of sow and fetus from day 35 to 70 of gestation. Toxicol. Lett. 2008, 179, 113–117. [Google Scholar] [CrossRef]
- Cowan, S.T. Bergey‘s Manual of Determinative Bacteriology. Nature 1948, 162, 833. [Google Scholar] [CrossRef]
- Ma, Q.G.; Zhao, L.H.; Ji, C.; Zhang, J.Y.; Li, M.L.; Zheng, R. A Strain Domestication Method for Improving the Degradation Efficiency of Mycotoxin-Degrading Bacteria. Patent CN10804 8385A, 2018.
- Duca, R.C.; Bravin, F.; Delaforge, M.; Vladescu, L.; Badea, I.A.; Criste, R.D. Development of a New HPLC Method Used for Determination of Zearalenone and Its Metabolites in Broiler Samples. Influence of Zearalenone on the Nutritional Properties of Broiler Meat. J. Agric. Food Chem. 2009, 57, 10497–10504. [Google Scholar] [CrossRef]

| Experimental Projects | ANSB010 1 | ANSB01G 2 | Experimental Projects | ANSB010 | ANSB01G |
|---|---|---|---|---|---|
| Gram | + | + | Glucose | + | + |
| Cell shape | Rod-shape | Rod-shape | Maltose | + | + |
| Cell diameter > 1 μm | + | + | Sucrose | + | + |
| Spore forming | + | + | D-xylose | + | + |
| Spore dilation | − | − | L-xylose | − | − |
| Round spores | − | − | D-arabinose | − | − |
| Glycerol | + | + | L-arabinose | + | + |
| Cellulose utilization | + | + | D-mannitol | + | + |
| Catalase | + | + | Gas production using glucose | − | − |
| Oxidase test | + | + | Citrate utilization | + | + |
| Anaerobic | − | − | Growth at 10 or 50 °C | − | − |
| Voges-Proskauer (VP) test | + | + | Growth at 37 °C | + | + |
| VP < pH 6 | + | + | Growth at pH 5.7 | + | + |
| VP > pH 7 | − | − | Growth on 7% NaCl | + | + |
| Methyl red test | − | − | Hydrolysis of starch | + | + |
| Gluconate | − | − | Decomposition of casein | + | + |
| Xylitol | − | − | Nitrate reduction | + | + |
| Indicator Bacteria | Antibacterial Circle Diameter (cm) | SEM | p-Value | ||
|---|---|---|---|---|---|
| Con | ANSB010 | ANSB01G | |||
| E. coli | 1.10 b | 1.76 a | 1.68 a | 0.07 | 0.00 |
| S. choleraesuis | 0.86 b | 1.62 a | 1.71 a | 0.09 | 0.00 |
| S. aureus | 1.07 b | 1.74 a | 1.71 a | 0.08 | 0.00 |
| Time | ANSB010 | ANSB01G | SEM | p-Value |
|---|---|---|---|---|
| 6 h | 0.05 b | 65.13 a | 12.23 | 0.00 |
| 24 h | 0.38 b | 92.57 a | 4.81 | 0.00 |
| 48 h | −0.26 b | 100.00 a | 4.22 | 0.00 |
| Items | NC | ZC | PB | DA | SEM | p-Value |
|---|---|---|---|---|---|---|
| Initial weight, kg | 63.43 | 64.14 | 64.11 | 64.4 | 1.78 | 0.99 |
| Terminal weight, kg | 84.05 | 84.98 | 85.12 | 86.00 | 1.72 | 0.93 |
| ADG, g | 825 | 834 | 841 | 864 | 29.69 | 0.85 |
| ADFI, g | 2151 | 2244 | 2114 | 2047 | 81.44 | 0.10 |
| F/G | 2.61 abc | 2.69 ab | 2.52 bc | 2.38 c | 0.08 | <0.01 |
| Items | NC | ZC | PB | DA | SEM | p-Value |
|---|---|---|---|---|---|---|
| Length, cm | 3.12 ab | 3.34 a | 2.93 ab | 2.85 b | 0.66 | 0.03 |
| Width, cm | 2.51 | 2.53 | 2.42 | 2.21 | 0.48 | 0.10 |
| Height, cm | 2.36 | 2.30 | 1.90 | 1.95 | 0.75 | 0.43 |
| Area, cm2 | 6.15 ab | 6.64 a | 5.58 ab | 4.99 b | 0.21 | 0.03 |
| Volume, cm3 | 4.83 ab | 5.11 a | 3.54 b | 3.23 c | 0.24 | 0.00 |
| Items | NC | ZC | PB | DA | SEM | p-Value |
|---|---|---|---|---|---|---|
| Content of ZEN in diet, μg/kg | 17.50 | 304.80 | 297.30 | 307.70 | 55.42 | 0.06 |
| Content of ZEN in feces, μg/kg | 7.23 b | 104.24 a | 98.86 a | 55.37 b | 17.34 | 0.00 |
| Ratio of ZEN contents between feces to diet, % | 41.34 | 34.20 | 33.26 | 17.30 | 5.87 | 0.73 |
| Ingredient | % | Nutrition Component | Content 1 |
|---|---|---|---|
| Maize | 57.00 | DE, Kcal/Kg | 3100 |
| Soybean meal | 23.00 | Crude protein, % | 17.00 |
| Wheat bran | 16.00 | Calcium, % | 0.76 |
| Calcium hydrophosphate | 1.00 | Total phosphorus, % | 0.61 |
| Limestone | 1.05 | Non-phytate phosphorus, % | 0.36 |
| Salt | 0.30 | Lysine, % | 0.85 |
| Threonine | 0.05 | Methionine, % | 0.52 |
| Lysine 70% | 0.60 | Threonine, % | 0.59 |
| Choline chloride | 0.12 | ||
| Chlortetracycline | 0.05 | ||
| Compound-premix 2 | 0.83 | ||
| Total | 100.00 |
Publisher’s Note: MDPI stays neutral with regard to jurisdictional claims in published maps and institutional affiliations. |
© 2021 by the authors. Licensee MDPI, Basel, Switzerland. This article is an open access article distributed under the terms and conditions of the Creative Commons Attribution (CC BY) license (https://creativecommons.org/licenses/by/4.0/).
Share and Cite
Shen, W.; Liu, Y.; Zhang, X.; Zhang, X.; Rong, X.; Zhao, L.; Ji, C.; Lei, Y.; Li, F.; Chen, J.; et al. Comparison of Ameliorative Effects between Probiotic and Biodegradable Bacillus subtilis on Zearalenone Toxicosis in Gilts. Toxins 2021, 13, 882. https://doi.org/10.3390/toxins13120882
Shen W, Liu Y, Zhang X, Zhang X, Rong X, Zhao L, Ji C, Lei Y, Li F, Chen J, et al. Comparison of Ameliorative Effects between Probiotic and Biodegradable Bacillus subtilis on Zearalenone Toxicosis in Gilts. Toxins. 2021; 13(12):882. https://doi.org/10.3390/toxins13120882
Chicago/Turabian StyleShen, Wenqiang, Yaojun Liu, Xinyue Zhang, Xiong Zhang, Xiaoping Rong, Lihong Zhao, Cheng Ji, Yuanpei Lei, Fengjuan Li, Jing Chen, and et al. 2021. "Comparison of Ameliorative Effects between Probiotic and Biodegradable Bacillus subtilis on Zearalenone Toxicosis in Gilts" Toxins 13, no. 12: 882. https://doi.org/10.3390/toxins13120882
APA StyleShen, W., Liu, Y., Zhang, X., Zhang, X., Rong, X., Zhao, L., Ji, C., Lei, Y., Li, F., Chen, J., & Ma, Q. (2021). Comparison of Ameliorative Effects between Probiotic and Biodegradable Bacillus subtilis on Zearalenone Toxicosis in Gilts. Toxins, 13(12), 882. https://doi.org/10.3390/toxins13120882

